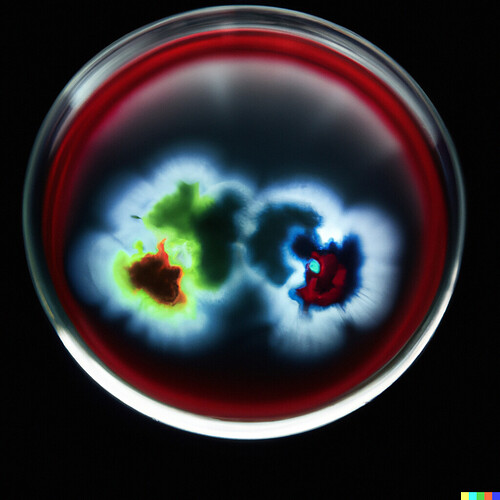

Dear community,
I have the following code to show an image via a url using st.markdown

Some links seem to work and others do not, I sincerely hope that you guys have an explanation for that.
Here is an example of a link that works:
And a link that doesn’t work:
Thanks for helping out,
Daan